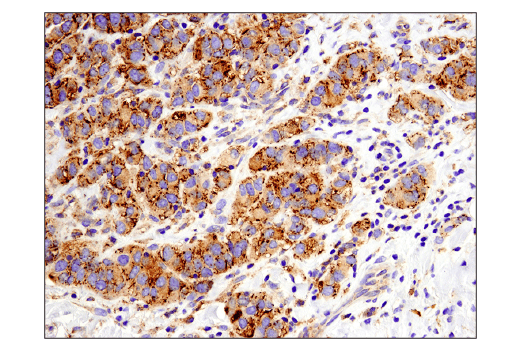
undefined Image 26: Host Cell Viral Restriction Factor Antibody Sampler Kit

Revision 1
#68355
Store at -20C
Host Cell Viral Restriction Factor Antibody Sampler Kit
1 Kit
(9 x 20 microliters)
877-616-CELL (2355)
877-678-TECH (8324)
3 Trask Lane | Danvers | Massachusetts | 01923 | USA
For Research Use Only. Not for Use in Diagnostic Procedures.
| Product Includes | Product # | Quantity | Mol. Wt | Isotype/Source |
|---|---|---|---|---|
| MX1 (D3W7I) Rabbit Monoclonal Antibody | 37849 | 20 µl | 76 kDa | Rabbit IgG |
| OAS1 (D1W3A) Rabbit Monoclonal Antibody | 14498 | 20 µl | 40, 44 kDa | Rabbit IgG |
| RNase L (D4B4J) Rabbit Monoclonal Antibody | 27281 | 20 µl | 80 kDa | Rabbit IgG |
| IFITM3 (D8E8G) Rabbit Monoclonal Antibody | 59212 | 20 µl | 13-15 kDa | Rabbit IgG |
| BST2 (D5V5Z) Rabbit Monoclonal Antibody | 19277 | 20 µl | 28-40 kDa | Rabbit IgG |
| TRIM5-alpha (D6Z8L) Rabbit Monoclonal Antibody | 14326 | 20 µl | 56 kDa | Rabbit IgG |
| Phospho-eIF2 alpha (Ser51) (D9G8) Rabbit Monoclonal Antibody | 3398 | 20 µl | 38 kDa | Rabbit IgG |
| Phospho-SAMHD1 (Thr592) (D7O2M) Rabbit Monoclonal Antibody | 89930 | 20 µl | 72 kDa | Rabbit IgG |
| IFITM1 Antibody | 13126 | 20 µl | 14 kDa | Rabbit |
| Anti-rabbit IgG, HRP-linked Antibody | 7074 | 100 µl | Goat |
Please visit cellsignal.com for individual component applications, species cross-reactivity, dilutions, protocols, and additional product information.
Description
Storage
Background
2’-5’-oligoadenylate synthetase 1 (OAS1) is an antiviral protein induced by type 1 interferon that plays a key role in the cellular innate immune response (3). The OAS1 enzyme produces a second messenger, 2’-5’-linked oligoadenylate, which binds to RNase L, which then degrades viral and cellular RNA (4). Research studies indicate that the OAS1 system inhibits protein synthesis and induces apoptosis in virally infected cells, which limits viral infection (5).
Interferon-induced transmembrane protein (IFITM) family members, IFITM1 and IFITM3, appear to function as viral restriction factors by preventing fusion of viral and host membranes (6,7).
BST2 (CD317, Tetherin, HM1.24) is a type II transmembrane glycoprotein functioning as a major mediator of the innate immune defense against the dissemination of enveloped viruses by tethering viron on the cell surface, preventing viral release (8).
TRIM5α blocks viral infection by interacting with the incoming viral capsid and promoting its premature disassembly (9).
PKR-induced phosphorylation of the eukaryotic initiation factor 2 (eIF2) α subunit at Ser51 is a well-documented mechanism to downregulate protein synthesis upon viral infection (10).
SAM domain and HD domain-containing protein 1 (SAMHD1) prevents autoimmunity and HIV infection by hydrolyzing intracellular deoxynucleoside triphosphates (dNTPs), thereby limiting inappropriate immune activation by self nucleic acid and inhibiting reverse transcription of the HIV genome (11). Phosphorylation of SAMHD1 at Thr592 by cyclin A2/CDK1 was identified as a regulatory mechanism that controls SAMHD1 activity. SAMHD1 is phosphorylated in proliferating cells, which inhibits its ability to block HIV infection (12).
Background References
- Staeheli, P. et al. (1986) Cell 44, 147-58.
- Kochs, G. and Haller, O. (1999) Proc Natl Acad Sci U S A 96, 2082-6.
- Schoggins, J.W. et al. (2011) Nature 472, 481-5.
- Dong, B. and Silverman, R.H. (1997) J Biol Chem 272, 22236-42.
- Castelli, J.C. et al. (1998) Cell Death Differ 5, 313-20.
- Brass, A.L. et al. (2009) Cell 139, 1243-54.
- Feeley, E.M. et al. (2011) PLoS Pathog 7, e1002337.
- Le Tortorec, A. et al. (2011) Viruses 3, 520-40.
- Stremlau, M. et al. (2006) Proc Natl Acad Sci U S A 103, 5514-9.
- Zamanian-Daryoush, M. et al. (2000) Mol Cell Biol 20, 1278-90.
- Powell, R.D. et al. (2011) J Biol Chem 286, 43596-600.
- Cribier, A. et al. (2013) Cell Rep 3, 1036-43.
Trademarks and Patents
Cell Signaling Technology is a trademark of Cell Signaling Technology, Inc.
All other trademarks are the property of their respective owners. Visit cellsignal.com/trademarks for more information.
Limited Uses
Except as otherwise expressly agreed in a writing signed by a legally authorized representative of CST, the following terms apply to Products provided by CST, its affiliates or its distributors. Any Customer's terms and conditions that are in addition to, or different from, those contained herein, unless separately accepted in writing by a legally authorized representative of CST, are rejected and are of no force or effect.
Products are labeled with For Research Use Only or a similar labeling statement and have not been approved, cleared, or licensed by the FDA or other regulatory foreign or domestic entity, for any purpose. Customer shall not use any Product for any diagnostic or therapeutic purpose, or otherwise in any manner that conflicts with its labeling statement. Products sold or licensed by CST are provided for Customer as the end-user and solely for research and development uses. Any use of Product for diagnostic, prophylactic or therapeutic purposes, or any purchase of Product for resale (alone or as a component) or other commercial purpose, requires a separate license from CST. Customer shall (a) not sell, license, loan, donate or otherwise transfer or make available any Product to any third party, whether alone or in combination with other materials, or use the Products to manufacture any commercial products, (b) not copy, modify, reverse engineer, decompile, disassemble or otherwise attempt to discover the underlying structure or technology of the Products, or use the Products for the purpose of developing any products or services that would compete with CST products or services, (c) not alter or remove from the Products any trademarks, trade names, logos, patent or copyright notices or markings, (d) use the Products solely in accordance with CST Product Terms of Sale and any applicable documentation, and (e) comply with any license, terms of service or similar agreement with respect to any third party products or services used by Customer in connection with the Products.
Revision 1



Revision 1



Revision 1



Revision 1



Revision 1



Revision 1



Revision 1



Revision 1



Revision 1

Revision 1



Revision 1



Revision 1



Revision 1



Revision 1
Simple Western™ analysis of HT-29 + hIFN⍺ -1 (10ng/mL, O/N) + poly(I:C )(2.5µg/mL, 7hr) + MG-132 (10µM, 7hr) lysates (0.1 mg/mL) using OAS1 (D1W3A) Rabbit mAb #14498. The virtual lane view (left) shows the target band (as indicated) at 1:10 and 1:50 dilutions of primary antibody. The corresponding electropherogram view (right) plots chemiluminescence by molecular weight along the capillary at 1:10 (blue line) and 1:50 (green line) dilutions of primary antibody. This experiment was performed under reducing conditions on the Jess™ Simple Western instrument from ProteinSimple, a BioTechne brand, using the 12-230 kDa separation module.



Revision 1
